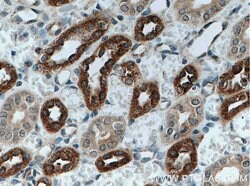
Uromodulin Rabbit anti-Human, Mouse, Rat, Polyclonal, Proteintech 20 &mu;L;

missing translation for 'onlineSavingsMsg'
Learn More
Learn More
Uromodulin Rabbit anti-Human, Mouse, Rat, Polyclonal, Proteintech
Rabbit Polyclonal Antibody
Brand: Proteintech 11911-1-AP-20UL
This item is not returnable.
View return policy
Description
This gene encodes uromodulin, the most abundant protein in normal urine. Its excretion in urine follows proteolytic cleavage of the ectodomain of its glycosyl phosphatidylinosital-anchored counterpart that is situated on the luminal cell surface of the loop of Henle. Uromodulin may act as a constitutive inhibitor of calcium crystallization in renal fluids. Excretion of uromodulin in urine may provide defense against urinary tract infections caused by uropathogenic bacteria. Defects in this gene are associated with the autosomal domit renal disorders medullary cystic kidney disease-2 (MCKD2) and familial juvenile hyperuricemic nephropathy (FJHN). These disorders are characterized by juvenile onset of hyperuricemia, gout, and progressive renal failure. While several transcript variants may exist for this gene, the full-length natures of only two have been described to date. These two represent the major variants of this gene and encode the same isoform.Specifications
| Uromodulin | |
| Polyclonal | |
| Unconjugated | |
| UMOD | |
| ADMCKD2, FJHN, HNFJ, MCKD2, THGP, THP, UMOD, uromodulin | |
| Rabbit | |
| Antigen Affinity Chromatography | |
| RUO | |
| 22242, 25128, 7369 | |
| -20°C | |
| Liquid |
| Immunohistochemistry (Paraffin), Immunoprecipitation, Western Blot | |
| 0.13 mg/mL | |
| PBS with 50% glycerol and 0.02% sodium azide; pH 7.3 | |
| P07911, P27590, Q91X17 | |
| UMOD | |
| Uromodulin Fusion Protein Ag2494 | |
| 20 μL | |
| Primary | |
| Human, Rat, Mouse | |
| Antibody | |
| IgG |
Product Content Correction
Your input is important to us. Please complete this form to provide feedback related to the content on this product.
Product Title
Spot an opportunity for improvement?Share a Content Correction